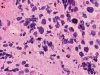
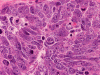

Squash
Squash
Squash
Squash
Frozen
Frozen







Synaptophysin
Neurofilament
GFAP
| A 8 year-old Boy with a
Mass in the Posterior Fossa. November, 2006, Case 611-1. |
Marc Harrison, M.D., Kar-Ming Fung, M.D., Ph.D. Last update: December 31, 2006.
Department of Pathology, University of Oklahoma Health Sciences Center, Oklahoma City, Oklahoma
Clinical information: The patient was an 8 year-old boy with two weeks history of headaches, nausea, vomiting, lethargy and fall to the right. A large, enhancing heterogeneous mass was demonstrated on MRI in the left cerebellar hemisphere with mass effect on the fourth ventricle. Mild hydrocephalus was also noted. The mass was excised. Representative images are shown as follow:
 |
 |
 |
 |
 |
|
|
|
A. Squash |
B. Squash |
C. Squash |
D. Squash |
E. Frozen |
F. Frozen |
|
 |
 |
 |
|
 |
 |
 |
| G. | H. | I. | J. |
K. Synaptophysin |
L. Neurofilament |
M. GFAP |
Pathology of the case:
The cytologic preparation demonstrates scattered to small clusters of small blue cells with a "dirty background" (Panel A). In general, the nuclei are round to oval and with a hyperchromatic, coarse salt and pepper like nucleoplasm. Many cells with pyknotic or apoptotic appearing nuclei are noted (Arrows in Panel A and B). A large, prominent nucleoli can be seen in many tumor cells (Arrow in Panel C). There is also large variation of tumor size (Panel D). The histopathologic picture of frozen sections (Panel D and E) is consistent with a small blue cell tumor. Note that the the nuclear details is poorly preserved. In general, nuclei of small blue cell tumors are much better demonstrated on cytologic preparation than frozen section. The frozen section, however, gives the overall architecture of the tumor.
On permanent sections, there is extensive necrosis (Panel G) and there are numerous small islands of pyknotic or apototic nuclei (Panel H). In non-necrotic areas, the nuclei are large and pleomorphic. There are numerous mitotic figures (Panel I). Nuclear wrapping (Arrow in Panel J) is readily seen. The tumor is focally positive for synaptophysin, neurofilament proteins, glial fibrillary acidic protein, and diffusely positive for antibody BAF47.
| DIAGNOSIS: Large cell (anaplastic) medulloblastoma, WHO grade IV. |
Discussion:
General Information
Medulloblastoma is a family of small blue cell tumors with phenotypic resemblance to the primitive neuroectoderm of the embryonal central nervous system (CNS) that occurs in the posterior fossa. They are the most common malignant brain tumors in infants and children with the peak incidence between 5-10 years of age. Over 75% of these tumors arise in the midline of the cerebellum. A small proportion of them are seen in young adults and it is not uncommon that these tumors are found slightly off the midline in the cerebellar hemisphere. The classic or conventional type of medulloblastoma has a 5-year survival rate of 60-80%. The two variants, desmoplastic medulloblastoma and medulloblastoblastoma with advanced neuronal development (also known as medulloblastoma with extensive nodularity) behave less aggressively than the classic form of medulloblastoma while large cell medulloblastoma (anaplastic medulloblastoma) behaves more aggressively. A family of small blue cell tumor with morphologic and immunohistochemical resemblance to medulloblastoma can occur outside the posterior fossa and are termed primitive neuroectodermal tumor (PNET) in the World Health Organizatgion (WHO) classification. Although these two families of tumors have superficial resemblance, they appear to be genetically different and have different demographic features.
The most common clinical manifestations, as expected from its anatomical location, are related to those of hydrocephalus and disturbance of cerebellar function. These include headache, gait disturbance, truncal ataxia, morning vomiting, and increase in head circumference if the tumor occurs in young infants. MRI typically shows a midline mass with heterogeneous enhancement. Medulloblastoma has a high tendency for cerebrospinal dissemination.Pathology
Macroscopically, medulloblastoma occurs as circumscribed, solid gray-white friable tissue mass which may extend to the surface of the cerebellar folia and involve the leptomeninges.
Discussion of the histopathology will be limited to the classic type and the large cell variant of medulloblastomas. Histologically, the classic variant is composed of solid sheets of small blue cells with small amount of cytoplasm. The nuclei are hyperpchromatic with resemblance of dried raisins or crumbled carrots under high magnification. Fine cytoplasmic processes know as neuropils can be seen. Although Homer Wright rosettes have been discussed, they are quite uncommon. Necrosis, if present, is not particularly extensive. Mitotic figures are common but atypical mitosis is not typically seen. Apoptotic or pyknotic nuclei are readily seen. [Click here to see images of a classic medulloblastoma]
Large cell (anaplastic) medulloblastoma is characterized by large, vesicular nuclei that are 5 times or more the size of a red blood cell. Marked variation in nuclear size and contour, and multinucleated, bizarre giant cells are other features. In particular, nuclear hugging or nuclear wrapping which refers one nucleus being surrounded by other nuclei as illustrated in this cases is a classic features of large cell medulloblastoma. In contrast to the classic type of medulloblastoma, the nucleoli are prominent, necrosis is prominent and extensive, extensive apoptotic or pyknotic cells are common. Large cell medulloblastomas have numerous mitotic figures that far exceed what would be expected in a classic medulloblastoma. Attempts has been made for a grading system of anaplstic changes in medulloblastoma 1 but the value of this system still has to stand the test of time 2, 3.
Immunohistochemistry, both classic and large cell variants are similar. They are almost always positive for synaptophysin. Some of them may express neurofilament proteins and glial fibrillary acidic protein (GFAP). Expression of photoreceptor specific markers including rhodopsin, S-antigen, inter-retinal binding protein (IRBP) have also been described. They are typically negative for epithelial membrane antigen. In contrast to glial neoplasms, mutation of p53 is quite uncommon in medulloblastoma. Isochromosome 17 is the most consistent genetic aberration. C-MYC gene amplification is also a common genetic alteration and has been shown to be related to anaplasia . Although studies have linked c-myc and N-myc gene overexpression with anaplasia and a poorer prognosis, this still appears somewhat controversial 4, 5, 6. Based on a study with gene expression profile 7, medulloblastoma with better prognosis are associated with expression of genes that influence cerebellar differentiation (incluing the TRKC and sodium channel gene) and extracellular matrix genes (including elastin and collagen type V gene). Expression of cell proliferation and gene metabolism (including MYBL2 and LDH) are associated with bad prognosis..
Differential Diagnosis:
In general, the differential diagnoses include a range of small blue cell tumors and its mimickers, namely ependymomal tumor including ependymoma, anaplastic ependymoma, and ependymoblastoma, atypical teratoid rhabdoid tumor (ATRT), choroid plexus carcinoma, metastatic carcinoma, and lymphoma.
The most common tumors in the posterior fossa in the pediatric age groups include the pilocytic astrocytoma, ependymoma, and medulloblastoma. ATRT is not uncommon but far from rare. Histologically, pilocytic astrocytoma is not in the small blue cell category [Click here to see a case of pilocytic astrocytom].
Ependymomal tumors typically form perivascular rossettes. Immunohistochemically, there is usually widespread and strong expression of GFAP and negative for synaptophysin. Positive staining for epithelial membrane antigen (EMA) can be seen particularly at the luminal borders of the cells. Electron microscopic features are also distinctive [Click here to see a case of ependymmoma]. Distinction of ependymal tumors from medulloblastoma is possible in most but not all of the cases during intraoperative consultation. In general, the cytologic preparations of ependymomas cling a lot of resemblance to a glial neoplasm such as astrocytoma. Elongated cytoplasmic processes are common. On the frozen sections, they are usually not as cellular as medulloblastoma. The number of mitotic figures, even in anaplastic ependymomas, are usually short of those in medulloblastoma. The perivascular arrangement is a good hint but may require some search in some cellular cases.
ATRT is essentially a rhabdoid tumor with or without non-rhabdoid element. It occurs most commonly in young infants under 3 years of age and are uncommon in older children. Histologically, the salient feature is the presence of rhabdoid cells. In many cases, a large population of non-rhabdoid cells most commonly in the form of medulloblastoma-like component is present. In these cases, the rhabdoid cells are not that numerous. In other cases, the tumor may be seen easily. ATRT is polyphenotypic on immunohistochemimstry. ATRT are positive for EMA which is a useful tool to differentiate them from medulloblastomas. In addition, all cells with rhabdoid morphology are strongly positive for vimentin. Demonstration of deletion of chromosome 22q by fluorescent in situ hybridization or negative immunoreactivity for BAF47 due to deletion of INI1 gene on chromosome 22q are great help for disgnosis of ATRT. [Click here to see a case of ATRT]
Choroid plexus carcinoma is one of the very few carcinoma that occurs predominantly in young infants and almost unknown in adults. They display the histologic stigmata of a carcinoma and grow in epithelial sheets. Their strong and diffuse expression of cytokeratin is a great help in differentiating them from medullobllastoma. It should be noted that medulloblastoma may express a small amount of cytokeratin and that choroid plexus tumors may be positive for synaptophysin. Expression of transthyretin in choroid plexus is a helpful diagnostic aid. However, the staining is not easy to be interpreted due to its presence in serum and the expression is quite variable.
Both lymphoma and metastatic carcinoma, particularly metastatic small cell carcinoma, can be distinguished from medulloblastooma quite easily by immunohistochemistry.
Reference:
Eberhart CG, Kepner JL, Goldthwaite PT, Kun LE, Duffner PK, Friedman HS, Strother DR, Burger PC. Histopathologic grading of medulloblastomas: a Pediatric Oncology Group study. Cancer. 2002 94:552-60.
Perry A. Medulloblastomas with favorable versus unfavorable histology: how many small blue cell tumor types are there in the brain? Adv Anat Pathol. 2002 Nov;9(6):345-50.
Giordana MT, D'Agostino C, Pollo B, Silvani A, Ferracini R, Paiolo A, Ghiglione P, Chio A. Anaplasia is rare and does not influence prognosis in adult medulloblastoma. J Neuropathol Exp Neurol. 2005 64:869-74.
Stearns D, Chaudhry A, Abel TW, Burger PC, Dang CV, Eberhart CG. c-myc overexpression causes anaplasia in medulloblastoma. Cancer Res. 2006 66:673-81.
Min HS, Lee YJ, Park K, Cho BK, Park SH. Medulloblastoma: histopathologic and molecular markers of anaplasia and biologic behavior. Acta Neuropathol (Berl). 2006 112:13-20.
Eberhart CG, Kratz JE, Schuster A, Goldthwaite P, Cohen KJ, Perlman EJ, Burger PC. Comparative genomic hybridization detects an increased number of chromosomal alterations in large cell/anaplastic medulloblastomas. Brain Pathol. 2002 12:36-44.
Pomeroy SL, Tamayo P, Gaasenbeek M et al. Prediction of central nervous system embryonal tumour outcome based on gene expression. Nature. 2002 415:436-42.